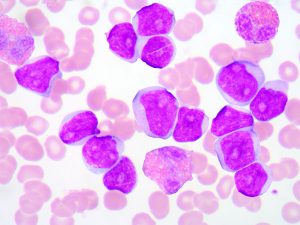
049 featured image
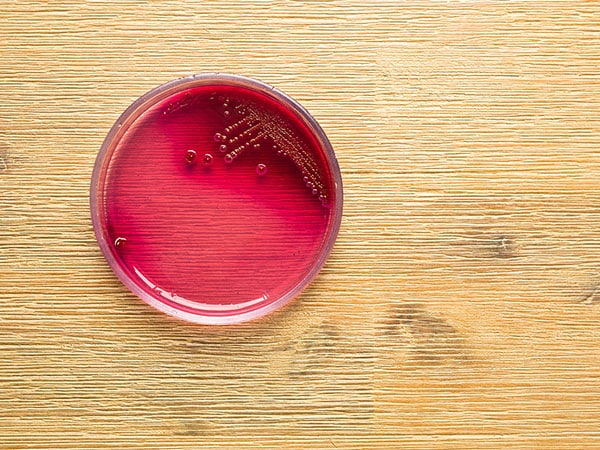
076 Featured image bacteria in culture

Blood Bank Guy Essentials Podcast
Current Episode:
104: Essentials of Transfusion Support in HPC Transplant with Brian Adkins
Hematopoietic progenitor cell (HPC) transplant continues to be used in more and more situations. In this episode, Dr. Brian Adkins outlines the many issues surrounding transfusion support in HPC transplant patients.
Previous Episodes:
103: Glaucomflecken! with Will and Kristin Flanary
Dr. Will Flanary, "Dr. Glaucomflecken," has a huge worldwide following for his hilarious medical videos. Will and his wife Kristin join me to share life stories behind the laughter.
102CE: Learn to Speak “Reference Lab” with Jan Hamilton
Understanding special techniques like adsorption, elution, and enzymes feels like learning a new language! Jan Hamilton is here to help you learn to speak "reference lab."
101CE: Look Before You Leap with Rich Haspel
New thoughts or ideas seem to pop up in transfusion medicine all the time. Dr. Rich Haspel has thoughts on how to evaluate the evidence, including his take on "low-titer group O whole blood" in trauma.
100CE: Pearls of Wisdom (Centennial Episode!)
This centennial episode marks a return of many previous guests, offering concise learning "pearls" for listeners of all levels.
099: Rh Immune Globulin (Teaching Episode)
Rh Immune Globulin prevents at-risk moms from making anti-D, but calculating proper dose can be challenging. Let's simplify things!
098CE: “Simply REDS” with Steve Kleinman & Cassandra Josephson
The REDS research project has transformed transfusion medicine, and the REDS-IV-P phase co-chairs say the best is yet to come!
097CE: Acute Normovolemic Hemodilution (ANH) with Steve Frank
Acute Normovolemic Hemodilution has a funny name and a shortage of data to support its use. Dr. Steve Frank shows us why it could be a great tool to reduce allogeneic red cell transfusion!
096CE: Navigating Blood Shortages with Claudia Cohn
Blood shortages happen, but the one associated with COVID-19 is unique. AABB Chief Medical Officer Dr. Claudia Cohn explains.
095CE: What is Liquid Plasma? with Chris Gresens
Plasma product names are confusing, but few are as misunderstood as Liquid Plasma. Dr. Chris Gresens explains why LP might be perfect for your transfusion service.
094CE: Thalassemia Essentials with Sujit Sheth
Thalassemia is an enormous global problem! Dr. Sujit Sheth is passionate about caring for patients with thalassemia, and he shares that passion with us in this special interview.
093CE: The Mighty MMA! with Sandy Nance
When red cell alloantibodies are unpredictable, the monocyte monolayer assay can clear things right up! Sandy Nance explains this very useful test.
092: When Platelet Transfusion Might Not Be Wise with Ruchika Goel
Platelet transfusions are life-saving in many situations, but what do you do when they might NOT be helpful?Platelets have been used to save the lives of patients with low platelet counts for decades. For the most part, they are considered a safe and effective...
091: Wholly Whole Blood, the Sequel! with Mark Yazer
In 2017, Mark Yazer told us all about “Low-titer Group O Whole Blood (LTOWB).” He's BACK to update us on the latest and greatest news.
090CE: RHD Genotyping; We Can Do Better! with Sue Johnson
RHD genotyping has not been as widely implemented as we had hoped. Sue Johnson is here to tell us why and how we can do better! NOTE: CE credit has expired for this episode.
089CE: The Transfused and the Breathless with Christine Cserti-Gazdewich
Cardiorespiratory transfusion reactions such as TACO and TRALI are deadly. Learn from an expert how to identify and manage them. NOTE: CE credit has expired for this episode.
088: Warm Autoantibody Best Practices with Alyssa Ziman and Meghan Delaney
Warm autoantibodies have a well-deserved reputation as tough challenges. Two experts show you some best practices to make things easier.
087CE: Transfusion-transmitted Infections with Suchi Pandey
Transfusion-transmitted infection is less likely today than ever, but that safety comes with a lot of effort. In this interview, you will learn current blood center strategies to keep blood safe. NOTE: CE credit has expired for this episode.
086CE: Scary Stories from the Transfusion Service with Mark Fung & Jay Hudgins
In this Halloween-themed episode, Mark Fung and Jay Hudgins describe how to handle intense transfusion service situations. NOTE: CE credit has expired for this episode.
085CE: What to do When Everything is Incompatible with Jill Storry
Uh-oh! Your patient needs blood, but EVERYTHING is incompatible! Jill Storry says, "Take it easy. Here's what to do next." NOTE: CE credit has expired for this episode.
084: COVID-19 Convalescent Plasma with Pampee Young and Ralph Vassallo
In the midst of the COVID-19 pandemic, does convalescent plasma from recovered patients offer fresh hope for those who are critically ill?
083CE: Building the Perfect Transfusion Committee with Carolyn Burns
Is your hospital transfusion committee doing what it should be doing? Carolyn Burns is back to help guide you to a better experience! NOTE: CE credit has expired for this episode.
082: COVID-19 and the Blood Supply with Louis Katz
Emergency episode! Blood banks, hospitals, and blood donors need to know what to do about COVID-19 now. Lou Katz explains. Recorded 3/16/20.
081CE: Top Ten Changes in the NEW AABB Standards with Rich Gammon
April 1, 2020 brings another AABB Standards update, and Standards Committee Chair Rich Gammon walks you through your action items. NOTE: CE credit has expired for this episode.
080CE: Is This Donor “Safe?” with Mindy Goldman
Safe blood donors, safe recipients: Mindy Goldman outlines Canada's decisions on older donors and men who have had sex with men. NOTE: CE credit has expired for this episode.
079: Pioneering Pathogen Reduction with Ray Goodrich
Long ago, pathogen reduction was just a dream, but pioneers like Ray Goodrich figured it out. He talks the past, present and future of PRT.
078CE: Does That Patient REALLY Need Platelets? with Joe Sweeney
Platelet transfusion decisions must Involve more than just the platelet count! Joe Sweeney explains how we can all make better choices. NOTE: CE credit has expired for this episode.
077CE: Implementing Pathogen-reduced Platelets with Pat Kopko
Pathogen-reduced platelets may soon be an attractive option for hospitals, but how do you implement them? Pat Kopko shares UCSD's solution! NOTE: CE credit has expired for this episode.
076: FDA Platelet Bacteria Guidance with Pat Kopko
The US FDA released the Final Guidance on bacteria in platelets on 9/30/19. Pat Kopko is here to help you understand what you need to do now.
075CE: What About Fibrinogen? with Melissa Cushing
Are we ignoring the most important coagulation factor when transfusing bleeding patients? Melissa Cushing asks, "What about fibrinogen?" NOTE: CE credit has expired for this episode.
074CE: Radioactive! with Chris Tormey
Irradiation prevents TA-GHVD, a lethal transfusion complication. But does it really do what you think it does? NOTE: CE credit has expired for this episode.
073: Implementing Trauma Whole Blood with David Oh and Mike Goodman
What's cold is hot again! You need to hear how one large US center implemented cold-stored whole blood for trauma transfusion.
072CE: Neonatal Platelet Transfusion with Martha Sola-Visner
What if everything we THOUGHT we knew about neonatal platelet transfusion is wrong? NOTE: CE credit has expired for this episode.
071: NEW Therapeutic Apheresis Guidelines with Nancy Dunbar
The new ASFA Guidelines for therapeutic apheresis treatment are now available. Here’s why you need to get your hands on them today!
070CE: Preventing Alloantibodies in Sickle Cell Disease with Stella Chou
Despite "matching," harmful RBC antibodies in patients with sickle cell disease still happen. Are we doing enough? Dr. Stella Chou details our next steps. NOTE: CE credit has expired for this episode.
069CE: Preventing TRALI with Beth Shaz
Blood centers have gone to great lengths in our efforts to prevent TRALI. Beth Shaz is here to explain what has and hasn't worked. NOTE: CE credit has expired for this episode.
068: Transfusion in Cardiac Surgery with Pierre Tibi
Cardiac surgery can be scary for blood banks! A busy cardiac surgeon pulls back the curtain on what is really happening in the OR!
067CE: Wiser Blood Management Choices with Carolyn Burns
While blood management is discussed everywhere today, your program may need to make wiser choices. Carolyn Burns shows you how. NOTE: CE credit has expired for this episode.
066: IgA Deficiency and Anaphylactic Reactions with Jerry Sandler
Here's what we thought we knew: IgA deficiency leads to anaphylactic transfusion reactions. Jerry Sandler says, "it's not that simple!"
065: Transfusion and Jehovah’s Witnesses with Jed Gorlin
Jehovah's Witnesses refuse transfusion based on religious beliefs, but blood bankers are still important in their care. Jed Gorlin shows us why.
064CE: Granulocyte Transfusions with Ron Strauss
Despite disappointing recent studies, Ron Strauss believes granulocyte concentrates still have an important role in modern Transfusion Medicine. NOTE: CE credit has expired for this episode.
063CE: Anti-CD47 Testing Interference with Connie Westhoff
Anti-CD47 is an exciting new cancer drug that totally messes up routine blood bank testing! Connie Westhoff shows how to get past the interference and keep patients safe. NOTE: CE credit has expired for this episode.
062CE: Autologous and Directed Donation with Julie Karp
Donating blood for your own use (autologous) or choosing your blood donor (directed donation) seems wise, but Julie Karp says, "not always!" NOTE: CE credit has expired for this episode.
061CE: Better AABB Assessments with Anne Chenoweth
You know all about AABB Standards, but how do you make them practical? Anne Chenoweth gives us tips to make your next AABB assessment better! NOTE: CE credit has expired for this episode.
060CE: Transforming Inventory Management with Nancy Dunbar
Nancy Dunbar says simple adjustments to "the rules" could reduce shortages of O-neg RBCs, AB plasma, and platelets! NOTE: CE credit has expired for this episode.
059: Antigen Matching for Future Moms with Meghan Delaney
Do females that could have babies in the future need to be matched for antigens like K to prevent HDFN? Meghan Delaney explains what she discovered in the "AMIGO Study."
058CE: Transfusion and Blood Clots with Ruchika Goel
Blood clots after surgery are a huge problem. Ruchika Goel explains the possible scary link between red cell transfusion and venous thromboembolism. NOTE: CE credit has expired for this episode.
057: Nonspecific Antibodies with Brenda Grossman
Isolated nonspecific reactions ("antibodies of undetermined specificity") on antibody workups are common and irritating, but are they important? Brenda Grossman explains.
056CE: Transfusion in Liver Disease with Jeannie Callum
Jeannie Callum says liver disease patients receive too much blood (almost 1 in every 5 blood products!), and shows us how to improve practice. NOTE: CE credit has expired for this episode.
055CE: 2017 Critical Developments with Claudia Cohn and Melissa Cushing
"I never KNEW about that paper!" All too common, right? Two editors of a synopsis of 2016-17 BB/TM literature summarize what you should know. NOTE: CE credit has expired for this episode.
054: ABO Discrepancies Essentials with Nicole Draper
By popular demand, it's time for ABO Discrepancies! Nicole Draper gives you three rules that will help you solve most of these cases.
053CE: Alloimmunization is a BIG Word! with Chris Tormey
Alloimmunization has been a mystery for decades, but Chris Tormey has new answers for why patients make antibodies we wish they didn't! NOTE: CE credit has expired for this episode.
052: Patient Blood Management: What Are You Missing? with Aryeh Shander
Your in-hospital blood management strategy may be perfect, but too late. Dr. Shander says preoperative anemia is a HUGE issue!
051: Product Choice and Compatibility Testing with Sue Johnson
Sue Johnson shows us how to choose compatible blood products and TEST them to make sure they are compatible (2 of 2).
050CE: Specimen Issues and Serologic Testing with Sue Johnson
Sue Johnson returns to explain specimen requirements and patient serologic testing (part 1 of 2). NOTE: CE credit has expired for this episode.
049CE: Red, White, and Yellow! with Jeff Winters
Urgent removal of WBCs, platelets, and RBCs (therapeutic cytapheresis) can be stressful, but Jeff Winters has tons of practical insights to share with all of us. NOTE: CE credit has expired for this episode.
048: Bloodless Medicine? with Steve Frank
Major surgery without transfusion? Is this possible? It's VERY possible, and Dr. Steve Frank from the Johns Hopkins Bloodless Medicine Program, shares tips on just how to do it!
047CE: I See CMV! with John Roback
How do we achieve "CMV-safe" blood? Dr. John Roback was senior author of an AABB report, and he's here to clear the air...maybe! NOTE: CE credit has expired for this episode.
046: Top 5 Changes in the NEW AABB Standards with Pat Ooley
Pat Ooley, Chair of the BBTS Standards Committee, outlines the top 5 changes in the 31st edition of AABB Standards (which went live April 1, 2018).
045: Past, Present, & Future with Harvey Klein
In 40+ years at the NIH, Dr. Harvey Klein has seen it all in Transfusion Medicine! Hear his fascinating stories and opinions on the Past, Present, & Future.
044CE: What I Wish I Knew! with Pat Kopko
Listen in as my friend of 30+ years, Pat Kopko, and I share tons of essential tips we wish we knew "way back when!" NOTE: CE credit has expired for this episode.
043CE: Practical Tips to Influence Transfusion Practice with Mark Fung
Can transfusion practice be changed? Maybe not, but it can be influenced, and Dr. Mark Fung explains how to do so! NOTE: CE credit has expired for this episode.
042: Do Clinicians Know Transfusion Medicine? with Rich Haspel
Do those making clinical decisions really know transfusion medicine? Rich Haspel and the BEST Collaborative identified the educational gaps!
041: Blood Donor Questions with Mary Townsend
Blood donors answer tons of predonation questions. Mary Townsend knows how those questions are developed, and she's here to explain.
040CE: “Wholly Whole Blood!” with Mark Yazer
You may think whole blood is a dinosaur, a relic of long-forgotten blood banks past. Mark Yazer wants to convince you otherwise! NOTE: CE credit has expired for this episode.
039CE: Understanding Febrile Reactions with Christine Cserti-Gazdewich
Febrile transfusion reactions are no big deal, right? Dr. Cserti-Gazdewich says, "Hold on! There's more to the story!" NOTE: CE credit has expired for this episode.
038: HDFN with Greg Denomme
Hemolytic Disease of the Fetus and Newborn (HDFN) seems simple, but there are lots of pitfalls! Greg Denomme guides us to HDFN clarity!
037: How to Learn with Justin Kreuter
What if everything we "know" about learning is wrong, and we need to change how we teach? Justin Kreuter "flips the classroom" to help us.
036: Group A Plasma in Trauma with Nancy Dunbar & Tait Stevens
Blood banks commonly use group A instead of AB plasma in trauma transfusion. Drs. Stevens & Dunbar share new evidence on whether this is safe!
035: Why Give Platelets? with Rick Kaufman
Platelets are tiny, but they can be a big issue! Dr. Rick Kaufman magnifies what the evidence shows about platelet transfusion.
034: Neonatal RBC Transfusion with Cassandra Josephson
Got lots of concerns about transfusing babies? Dr. Cassandra Josephson guides you through 5 essential neonatal RBC transfusion questions.
033: Straight Talk with an ER Physician with Scott Weingart
Tense relationship between blood bank and ER? Dr. Scott Weingart (a world-renowned Emergency Medicine physician) joins me to clear the air!
032: Eat Your Spinach? Donors and Iron with Jed Gorlin
"Have a steak! Eat your spinach!" Does that advice help donors? Jed Gorlin shows us why the old iron ways may not best!
031: Why All Blood Bankers Should Be on Twitter
Twitter is great for both young and "old" blood bankers. This roundtable discussion explains why you should dive in!
030: Antibodies in Sickle Cell with Eric Gehrie
Dr. Eric Gehrie explains why transfusing patients with sickle cell disease is challenging, especially in regard to alloimmunization.
029: Molecular Testing with Meghan Delaney
Molecular testing is everywhere in medicine today, and the blood bank is no exception! Meghan Delaney shows us how it all fits.
028: Who DAT? with Sue Johnson
For what is really a simple test, the Direct Antiglobulin Test (DAT) can be surprisingly confusing and complex. Sue Johnson is here to guide us to clarity!
027: NAIT with Brian Curtis
Is Neonatal Alloimmune Thrombocytopenia (NAIT) just the platelet version of Hemolytic Disease of the Newborn? Not quite! Dr. Brian Curtis helps us not hate NAIT!
026: Treating TTP with Jeff Winters
Continuing the discussion from BBGE 025, Jeff Winters explains a true emergency: Thrombotic Thrombocytopenic Purpura (TTP).
025: Intro to Therapeutic Apheresis with Jeff Winters
Therapeutic apheresis doesn't have to be scary! Dr. Jeff Winters is an enthusiastic and willing guide, and he gives us the Essentials!
024: Allergic Reactions with Will Savage
YAWN…Do you still think allergic reactions are benign and boring? Dr. Will Savage is here to explain why they are actually a big deal!
023: RBC Transfusion Guidelines with Jeff Carson
Whither RBCs? There’s no one better than lead author Dr. Jeff Carson to discuss the 2016 AABB RBC transfusion threshold recommendations!
022: Age of Blood with Nancy Heddle
Nancy Heddle is lead author of a landmark study analyzing age of blood and mortality. This "INFORMative" discussion may surprise you!
021: TACO with Garrett Booth
TACO is under-diagnosed, under-reported, and under-respected! Dr. Garrett Booth is here to help you understand the "ins and outs" of TACO.
020: Pathogen Inactivation with Jeff McCullough
Dr. Jeff McCullough discusses how to treat blood to zap most all of the "bugs in the bag," a process called pathogen inactivation.
019: Cryoprecipitate with Joe Chaffin
Cryoprecipitate: Still used in the US, but not widely understood! Dr. Chaffin answers common questions and addresses common CRYO myths!
018: Transfusion Premedication with Heidi Shafi
Many providers routinely give pretransfusion acetaminophen/diphenhydramine. Dr. Shafi explains why this might not be a great idea.
017: Transfusion Reactions with Mark Fung
All who transfuse or issue blood must understand the complications that can occur. Dr. Mark Fung gives us a straightforward approach.
016: Plasma Transfusion with Jeannie Callum
As many as 50% of plasma transfusions are unnecessary or inappropriate! You need to know why, and Dr. Jeannie Callum explains it SO well!
015 & 015-1: Zika Virus with Joe Chaffin
Zika virus is a really big issue for blood centers and hospitals (among others!). These two 2016 episodes hit the basics and beyond.
014: Patient Blood Management with Emily Volk
Patient blood management is not “coming,” it’s already HERE! Hospitals everywhere are starting PBM programs; what should YOURS do now?
013: TA-GVHD with Joe Chaffin
Transfusion-associated graft-vs-host disease is a dangerous transfusion complication! Learn how to prevent and hopefully never see TA-GVHD.
012: Pediatric Transfusion with Cassandra Josephson
Infants and children are NOT just "little adults!" Dr. Cassandra Josephson shares 5 principles you must know about pediatric transfusion.
011: Drug-induced Immune Hemolysis with Pat Arndt
Drug-induced immune hemolytic anemia seems complicated (and it can be!). Pat Arndt dispenses some clear guidance to treat your confusion!
010: Daratumumab Effect with Rick Kaufman
Daratumumab…Funny name, promising drug! Dr. Rick Kaufman is an authority on DARA’s confusing effects on BB testing, and he’s here to help.
009: Awesome Presentations with Kristine Krafts
It's easy to give a lousy presentation, but doing it right is SO much better! Kristine Krafts has 5 tips for AMAZING presentations!
008: Mythbusters with Kevin Land
Myths: Commonly held but incorrect beliefs. Dr. Kevin Land has the experience and expertise to “bust” some blood bank mythological ideas!
007: Massive Transfusion with Minh-Ha Tran
Massive transfusion sounds scary! Dr. Tran makes it better by explaining the "Who, Where, What, Why, When, and How” of Massive Transfusion.
006: Ask BBGuy Mailbag
Dr. Chaffin opens the BBGuy mailbag to discuss D variants, Liquid Plasma, warm autoantibody issues, and directed donor blood collections.
005: Rh Genotyping with Connie Westhoff
You should be using RHD genotyping, says Dr. Connie Westhoff, in particular in patients with unexpected results on serologic D typing. Learn why here.
004: Tough Transfusion Choices with Magali Fontaine
Dr. Magali Fontaine breaks down some challenging transfusion service issues, including CMV, ABO issues with platelets, and age of blood.
003: Septic Reactions with Anne Eder
Bacterially-tainted platelet units are FAR more common than other transfusion infections! Dr. Anne Eder outlines the problem and solutions.
002: Platelet Refractoriness with Pat Kopko
Platelet refractoriness is a common headache. Dr. Pat Kopko spells out a practical approach to patients who don’t respond to platelets.
001: Whole Blood Platelets with Mark Yazer
Dr. Mark Yazer explodes some of the persistent misconceptions that blood bankers and clinicians have about whole blood-derived platelets!
000: Introduction with Joe Chaffin
Welcome to the Blood Bank Guy Essentials Podcast, a new project from Joe Chaffin! This quick episode tells you what to expect and learn.
103: Glaucomflecken! with Will and Kristin Flanary
Dr. Will Flanary, "Dr. Glaucomflecken," has a huge worldwide following for his hilarious medical videos. Will and his wife Kristin join me to share life stories behind the laughter.
102CE: Learn to Speak “Reference Lab” with Jan Hamilton
Understanding special techniques like adsorption, elution, and enzymes feels like learning a new language! Jan Hamilton is here to help you learn to speak "reference lab."
101CE: Look Before You Leap with Rich Haspel
New thoughts or ideas seem to pop up in transfusion medicine all the time. Dr. Rich Haspel has thoughts on how to evaluate the evidence, including his take on "low-titer group O whole blood" in trauma.
100CE: Pearls of Wisdom (Centennial Episode!)
This centennial episode marks a return of many previous guests, offering concise learning "pearls" for listeners of all levels.
099: Rh Immune Globulin (Teaching Episode)
Rh Immune Globulin prevents at-risk moms from making anti-D, but calculating proper dose can be challenging. Let's simplify things!
098CE: “Simply REDS” with Steve Kleinman & Cassandra Josephson
The REDS research project has transformed transfusion medicine, and the REDS-IV-P phase co-chairs say the best is yet to come!
097CE: Acute Normovolemic Hemodilution (ANH) with Steve Frank
Acute Normovolemic Hemodilution has a funny name and a shortage of data to support its use. Dr. Steve Frank shows us why it could be a great tool to reduce allogeneic red cell transfusion!
096CE: Navigating Blood Shortages with Claudia Cohn
Blood shortages happen, but the one associated with COVID-19 is unique. AABB Chief Medical Officer Dr. Claudia Cohn explains.
095CE: What is Liquid Plasma? with Chris Gresens
Plasma product names are confusing, but few are as misunderstood as Liquid Plasma. Dr. Chris Gresens explains why LP might be perfect for your transfusion service.
094CE: Thalassemia Essentials with Sujit Sheth
Thalassemia is an enormous global problem! Dr. Sujit Sheth is passionate about caring for patients with thalassemia, and he shares that passion with us in this special interview.
093CE: The Mighty MMA! with Sandy Nance
When red cell alloantibodies are unpredictable, the monocyte monolayer assay can clear things right up! Sandy Nance explains this very useful test.
092: When Platelet Transfusion Might Not Be Wise with Ruchika Goel
Platelet transfusions are life-saving in many situations, but what do you do when they might NOT be helpful?Platelets have been used to save the lives of patients with low platelet counts for decades. For the most part, they are considered a safe and effective...
091: Wholly Whole Blood, the Sequel! with Mark Yazer
In 2017, Mark Yazer told us all about “Low-titer Group O Whole Blood (LTOWB).” He's BACK to update us on the latest and greatest news.
090CE: RHD Genotyping; We Can Do Better! with Sue Johnson
RHD genotyping has not been as widely implemented as we had hoped. Sue Johnson is here to tell us why and how we can do better! NOTE: CE credit has expired for this episode.
089CE: The Transfused and the Breathless with Christine Cserti-Gazdewich
Cardiorespiratory transfusion reactions such as TACO and TRALI are deadly. Learn from an expert how to identify and manage them. NOTE: CE credit has expired for this episode.
088: Warm Autoantibody Best Practices with Alyssa Ziman and Meghan Delaney
Warm autoantibodies have a well-deserved reputation as tough challenges. Two experts show you some best practices to make things easier.
087CE: Transfusion-transmitted Infections with Suchi Pandey
Transfusion-transmitted infection is less likely today than ever, but that safety comes with a lot of effort. In this interview, you will learn current blood center strategies to keep blood safe. NOTE: CE credit has expired for this episode.
086CE: Scary Stories from the Transfusion Service with Mark Fung & Jay Hudgins
In this Halloween-themed episode, Mark Fung and Jay Hudgins describe how to handle intense transfusion service situations. NOTE: CE credit has expired for this episode.
085CE: What to do When Everything is Incompatible with Jill Storry
Uh-oh! Your patient needs blood, but EVERYTHING is incompatible! Jill Storry says, "Take it easy. Here's what to do next." NOTE: CE credit has expired for this episode.
084: COVID-19 Convalescent Plasma with Pampee Young and Ralph Vassallo
In the midst of the COVID-19 pandemic, does convalescent plasma from recovered patients offer fresh hope for those who are critically ill?
083CE: Building the Perfect Transfusion Committee with Carolyn Burns
Is your hospital transfusion committee doing what it should be doing? Carolyn Burns is back to help guide you to a better experience! NOTE: CE credit has expired for this episode.
082: COVID-19 and the Blood Supply with Louis Katz
Emergency episode! Blood banks, hospitals, and blood donors need to know what to do about COVID-19 now. Lou Katz explains. Recorded 3/16/20.
081CE: Top Ten Changes in the NEW AABB Standards with Rich Gammon
April 1, 2020 brings another AABB Standards update, and Standards Committee Chair Rich Gammon walks you through your action items. NOTE: CE credit has expired for this episode.
080CE: Is This Donor “Safe?” with Mindy Goldman
Safe blood donors, safe recipients: Mindy Goldman outlines Canada's decisions on older donors and men who have had sex with men. NOTE: CE credit has expired for this episode.
079: Pioneering Pathogen Reduction with Ray Goodrich
Long ago, pathogen reduction was just a dream, but pioneers like Ray Goodrich figured it out. He talks the past, present and future of PRT.
078CE: Does That Patient REALLY Need Platelets? with Joe Sweeney
Platelet transfusion decisions must Involve more than just the platelet count! Joe Sweeney explains how we can all make better choices. NOTE: CE credit has expired for this episode.
077CE: Implementing Pathogen-reduced Platelets with Pat Kopko
Pathogen-reduced platelets may soon be an attractive option for hospitals, but how do you implement them? Pat Kopko shares UCSD's solution! NOTE: CE credit has expired for this episode.
076: FDA Platelet Bacteria Guidance with Pat Kopko
The US FDA released the Final Guidance on bacteria in platelets on 9/30/19. Pat Kopko is here to help you understand what you need to do now.
075CE: What About Fibrinogen? with Melissa Cushing
Are we ignoring the most important coagulation factor when transfusing bleeding patients? Melissa Cushing asks, "What about fibrinogen?" NOTE: CE credit has expired for this episode.
074CE: Radioactive! with Chris Tormey
Irradiation prevents TA-GHVD, a lethal transfusion complication. But does it really do what you think it does? NOTE: CE credit has expired for this episode.
073: Implementing Trauma Whole Blood with David Oh and Mike Goodman
What's cold is hot again! You need to hear how one large US center implemented cold-stored whole blood for trauma transfusion.
072CE: Neonatal Platelet Transfusion with Martha Sola-Visner
What if everything we THOUGHT we knew about neonatal platelet transfusion is wrong? NOTE: CE credit has expired for this episode.
071: NEW Therapeutic Apheresis Guidelines with Nancy Dunbar
The new ASFA Guidelines for therapeutic apheresis treatment are now available. Here’s why you need to get your hands on them today!
070CE: Preventing Alloantibodies in Sickle Cell Disease with Stella Chou
Despite "matching," harmful RBC antibodies in patients with sickle cell disease still happen. Are we doing enough? Dr. Stella Chou details our next steps. NOTE: CE credit has expired for this episode.
069CE: Preventing TRALI with Beth Shaz
Blood centers have gone to great lengths in our efforts to prevent TRALI. Beth Shaz is here to explain what has and hasn't worked. NOTE: CE credit has expired for this episode.
068: Transfusion in Cardiac Surgery with Pierre Tibi
Cardiac surgery can be scary for blood banks! A busy cardiac surgeon pulls back the curtain on what is really happening in the OR!
067CE: Wiser Blood Management Choices with Carolyn Burns
While blood management is discussed everywhere today, your program may need to make wiser choices. Carolyn Burns shows you how. NOTE: CE credit has expired for this episode.
066: IgA Deficiency and Anaphylactic Reactions with Jerry Sandler
Here's what we thought we knew: IgA deficiency leads to anaphylactic transfusion reactions. Jerry Sandler says, "it's not that simple!"
065: Transfusion and Jehovah’s Witnesses with Jed Gorlin
Jehovah's Witnesses refuse transfusion based on religious beliefs, but blood bankers are still important in their care. Jed Gorlin shows us why.
064CE: Granulocyte Transfusions with Ron Strauss
Despite disappointing recent studies, Ron Strauss believes granulocyte concentrates still have an important role in modern Transfusion Medicine. NOTE: CE credit has expired for this episode.
063CE: Anti-CD47 Testing Interference with Connie Westhoff
Anti-CD47 is an exciting new cancer drug that totally messes up routine blood bank testing! Connie Westhoff shows how to get past the interference and keep patients safe. NOTE: CE credit has expired for this episode.
062CE: Autologous and Directed Donation with Julie Karp
Donating blood for your own use (autologous) or choosing your blood donor (directed donation) seems wise, but Julie Karp says, "not always!" NOTE: CE credit has expired for this episode.
061CE: Better AABB Assessments with Anne Chenoweth
You know all about AABB Standards, but how do you make them practical? Anne Chenoweth gives us tips to make your next AABB assessment better! NOTE: CE credit has expired for this episode.
060CE: Transforming Inventory Management with Nancy Dunbar
Nancy Dunbar says simple adjustments to "the rules" could reduce shortages of O-neg RBCs, AB plasma, and platelets! NOTE: CE credit has expired for this episode.
059: Antigen Matching for Future Moms with Meghan Delaney
Do females that could have babies in the future need to be matched for antigens like K to prevent HDFN? Meghan Delaney explains what she discovered in the "AMIGO Study."
058CE: Transfusion and Blood Clots with Ruchika Goel
Blood clots after surgery are a huge problem. Ruchika Goel explains the possible scary link between red cell transfusion and venous thromboembolism. NOTE: CE credit has expired for this episode.
057: Nonspecific Antibodies with Brenda Grossman
Isolated nonspecific reactions ("antibodies of undetermined specificity") on antibody workups are common and irritating, but are they important? Brenda Grossman explains.
056CE: Transfusion in Liver Disease with Jeannie Callum
Jeannie Callum says liver disease patients receive too much blood (almost 1 in every 5 blood products!), and shows us how to improve practice. NOTE: CE credit has expired for this episode.
055CE: 2017 Critical Developments with Claudia Cohn and Melissa Cushing
"I never KNEW about that paper!" All too common, right? Two editors of a synopsis of 2016-17 BB/TM literature summarize what you should know. NOTE: CE credit has expired for this episode.
054: ABO Discrepancies Essentials with Nicole Draper
By popular demand, it's time for ABO Discrepancies! Nicole Draper gives you three rules that will help you solve most of these cases.
053CE: Alloimmunization is a BIG Word! with Chris Tormey
Alloimmunization has been a mystery for decades, but Chris Tormey has new answers for why patients make antibodies we wish they didn't! NOTE: CE credit has expired for this episode.
052: Patient Blood Management: What Are You Missing? with Aryeh Shander
Your in-hospital blood management strategy may be perfect, but too late. Dr. Shander says preoperative anemia is a HUGE issue!
051: Product Choice and Compatibility Testing with Sue Johnson
Sue Johnson shows us how to choose compatible blood products and TEST them to make sure they are compatible (2 of 2).
050CE: Specimen Issues and Serologic Testing with Sue Johnson
Sue Johnson returns to explain specimen requirements and patient serologic testing (part 1 of 2). NOTE: CE credit has expired for this episode.
049CE: Red, White, and Yellow! with Jeff Winters
Urgent removal of WBCs, platelets, and RBCs (therapeutic cytapheresis) can be stressful, but Jeff Winters has tons of practical insights to share with all of us. NOTE: CE credit has expired for this episode.
048: Bloodless Medicine? with Steve Frank
Major surgery without transfusion? Is this possible? It's VERY possible, and Dr. Steve Frank from the Johns Hopkins Bloodless Medicine Program, shares tips on just how to do it!
047CE: I See CMV! with John Roback
How do we achieve "CMV-safe" blood? Dr. John Roback was senior author of an AABB report, and he's here to clear the air...maybe! NOTE: CE credit has expired for this episode.
046: Top 5 Changes in the NEW AABB Standards with Pat Ooley
Pat Ooley, Chair of the BBTS Standards Committee, outlines the top 5 changes in the 31st edition of AABB Standards (which went live April 1, 2018).
045: Past, Present, & Future with Harvey Klein
In 40+ years at the NIH, Dr. Harvey Klein has seen it all in Transfusion Medicine! Hear his fascinating stories and opinions on the Past, Present, & Future.
044CE: What I Wish I Knew! with Pat Kopko
Listen in as my friend of 30+ years, Pat Kopko, and I share tons of essential tips we wish we knew "way back when!" NOTE: CE credit has expired for this episode.
043CE: Practical Tips to Influence Transfusion Practice with Mark Fung
Can transfusion practice be changed? Maybe not, but it can be influenced, and Dr. Mark Fung explains how to do so! NOTE: CE credit has expired for this episode.
042: Do Clinicians Know Transfusion Medicine? with Rich Haspel
Do those making clinical decisions really know transfusion medicine? Rich Haspel and the BEST Collaborative identified the educational gaps!
041: Blood Donor Questions with Mary Townsend
Blood donors answer tons of predonation questions. Mary Townsend knows how those questions are developed, and she's here to explain.
040CE: “Wholly Whole Blood!” with Mark Yazer
You may think whole blood is a dinosaur, a relic of long-forgotten blood banks past. Mark Yazer wants to convince you otherwise! NOTE: CE credit has expired for this episode.
039CE: Understanding Febrile Reactions with Christine Cserti-Gazdewich
Febrile transfusion reactions are no big deal, right? Dr. Cserti-Gazdewich says, "Hold on! There's more to the story!" NOTE: CE credit has expired for this episode.
038: HDFN with Greg Denomme
Hemolytic Disease of the Fetus and Newborn (HDFN) seems simple, but there are lots of pitfalls! Greg Denomme guides us to HDFN clarity!
037: How to Learn with Justin Kreuter
What if everything we "know" about learning is wrong, and we need to change how we teach? Justin Kreuter "flips the classroom" to help us.
036: Group A Plasma in Trauma with Nancy Dunbar & Tait Stevens
Blood banks commonly use group A instead of AB plasma in trauma transfusion. Drs. Stevens & Dunbar share new evidence on whether this is safe!
035: Why Give Platelets? with Rick Kaufman
Platelets are tiny, but they can be a big issue! Dr. Rick Kaufman magnifies what the evidence shows about platelet transfusion.
034: Neonatal RBC Transfusion with Cassandra Josephson
Got lots of concerns about transfusing babies? Dr. Cassandra Josephson guides you through 5 essential neonatal RBC transfusion questions.
033: Straight Talk with an ER Physician with Scott Weingart
Tense relationship between blood bank and ER? Dr. Scott Weingart (a world-renowned Emergency Medicine physician) joins me to clear the air!
032: Eat Your Spinach? Donors and Iron with Jed Gorlin
"Have a steak! Eat your spinach!" Does that advice help donors? Jed Gorlin shows us why the old iron ways may not best!
031: Why All Blood Bankers Should Be on Twitter
Twitter is great for both young and "old" blood bankers. This roundtable discussion explains why you should dive in!
030: Antibodies in Sickle Cell with Eric Gehrie
Dr. Eric Gehrie explains why transfusing patients with sickle cell disease is challenging, especially in regard to alloimmunization.
029: Molecular Testing with Meghan Delaney
Molecular testing is everywhere in medicine today, and the blood bank is no exception! Meghan Delaney shows us how it all fits.
028: Who DAT? with Sue Johnson
For what is really a simple test, the Direct Antiglobulin Test (DAT) can be surprisingly confusing and complex. Sue Johnson is here to guide us to clarity!
027: NAIT with Brian Curtis
Is Neonatal Alloimmune Thrombocytopenia (NAIT) just the platelet version of Hemolytic Disease of the Newborn? Not quite! Dr. Brian Curtis helps us not hate NAIT!
026: Treating TTP with Jeff Winters
Continuing the discussion from BBGE 025, Jeff Winters explains a true emergency: Thrombotic Thrombocytopenic Purpura (TTP).
025: Intro to Therapeutic Apheresis with Jeff Winters
Therapeutic apheresis doesn't have to be scary! Dr. Jeff Winters is an enthusiastic and willing guide, and he gives us the Essentials!
024: Allergic Reactions with Will Savage
YAWN…Do you still think allergic reactions are benign and boring? Dr. Will Savage is here to explain why they are actually a big deal!
023: RBC Transfusion Guidelines with Jeff Carson
Whither RBCs? There’s no one better than lead author Dr. Jeff Carson to discuss the 2016 AABB RBC transfusion threshold recommendations!
022: Age of Blood with Nancy Heddle
Nancy Heddle is lead author of a landmark study analyzing age of blood and mortality. This "INFORMative" discussion may surprise you!
021: TACO with Garrett Booth
TACO is under-diagnosed, under-reported, and under-respected! Dr. Garrett Booth is here to help you understand the "ins and outs" of TACO.
020: Pathogen Inactivation with Jeff McCullough
Dr. Jeff McCullough discusses how to treat blood to zap most all of the "bugs in the bag," a process called pathogen inactivation.
019: Cryoprecipitate with Joe Chaffin
Cryoprecipitate: Still used in the US, but not widely understood! Dr. Chaffin answers common questions and addresses common CRYO myths!
018: Transfusion Premedication with Heidi Shafi
Many providers routinely give pretransfusion acetaminophen/diphenhydramine. Dr. Shafi explains why this might not be a great idea.
017: Transfusion Reactions with Mark Fung
All who transfuse or issue blood must understand the complications that can occur. Dr. Mark Fung gives us a straightforward approach.
016: Plasma Transfusion with Jeannie Callum
As many as 50% of plasma transfusions are unnecessary or inappropriate! You need to know why, and Dr. Jeannie Callum explains it SO well!
015 & 015-1: Zika Virus with Joe Chaffin
Zika virus is a really big issue for blood centers and hospitals (among others!). These two 2016 episodes hit the basics and beyond.
014: Patient Blood Management with Emily Volk
Patient blood management is not “coming,” it’s already HERE! Hospitals everywhere are starting PBM programs; what should YOURS do now?
013: TA-GVHD with Joe Chaffin
Transfusion-associated graft-vs-host disease is a dangerous transfusion complication! Learn how to prevent and hopefully never see TA-GVHD.
012: Pediatric Transfusion with Cassandra Josephson
Infants and children are NOT just "little adults!" Dr. Cassandra Josephson shares 5 principles you must know about pediatric transfusion.
011: Drug-induced Immune Hemolysis with Pat Arndt
Drug-induced immune hemolytic anemia seems complicated (and it can be!). Pat Arndt dispenses some clear guidance to treat your confusion!
010: Daratumumab Effect with Rick Kaufman
Daratumumab…Funny name, promising drug! Dr. Rick Kaufman is an authority on DARA’s confusing effects on BB testing, and he’s here to help.
009: Awesome Presentations with Kristine Krafts
It's easy to give a lousy presentation, but doing it right is SO much better! Kristine Krafts has 5 tips for AMAZING presentations!
008: Mythbusters with Kevin Land
Myths: Commonly held but incorrect beliefs. Dr. Kevin Land has the experience and expertise to “bust” some blood bank mythological ideas!
007: Massive Transfusion with Minh-Ha Tran
Massive transfusion sounds scary! Dr. Tran makes it better by explaining the "Who, Where, What, Why, When, and How” of Massive Transfusion.
006: Ask BBGuy Mailbag
Dr. Chaffin opens the BBGuy mailbag to discuss D variants, Liquid Plasma, warm autoantibody issues, and directed donor blood collections.
005: Rh Genotyping with Connie Westhoff
You should be using RHD genotyping, says Dr. Connie Westhoff, in particular in patients with unexpected results on serologic D typing. Learn why here.
004: Tough Transfusion Choices with Magali Fontaine
Dr. Magali Fontaine breaks down some challenging transfusion service issues, including CMV, ABO issues with platelets, and age of blood.